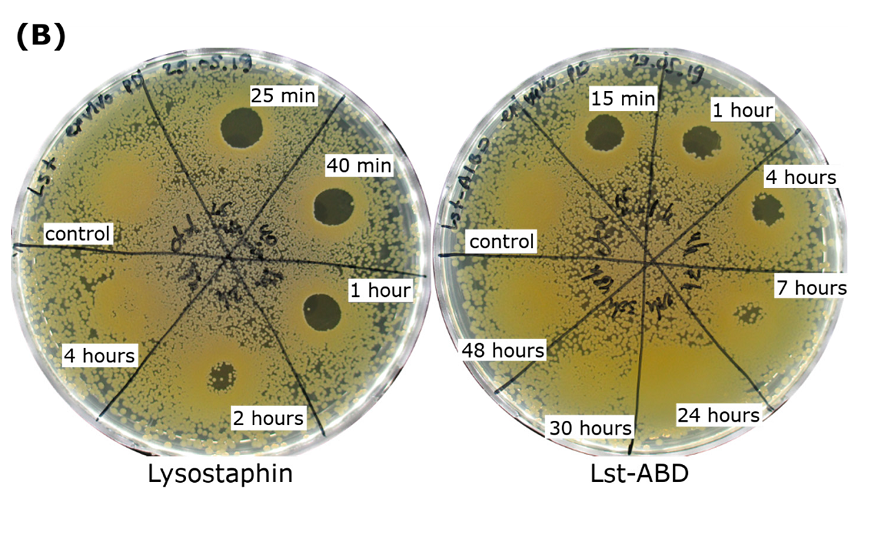

Антибактериальные лизины могут уничтожать как чувствительные, так и антибиотикорезистентные штаммы. Эти белки способны разлагать пептидогликаны клеточной стенки бактерий, вызывая их гибель. Однако лизины обладают одним значительным ограничением: их пребывание в кровотоке длится очень недолго. С другой стороны, модификация белка полиэтиленгликолем увеличивает период их полужизни в плазме (время, необходимое для того, чтобы концентрация белка в плазме снизилась вдвое), но сводит на нет их активность.
Российские ученые сконструировали гибридный белок на основе лизостафина (лизина с сильной противостафилококковой активностью) и альбумин-связывающего домена от G-белка стрептококка. Получившийся белок оказался менее активным, чем лизостафин, но все еще сохранял заметное антибактериальное действие, тогда как период его полужизни в плазме у крыс возрос впятеро, что сделало пептидазу в 115 раз более эффективной.
Увеличение времени циркуляции белка в крови компенсировало его снизившуюся активность. Плазма крыс, получивших инъекцию гибридного белка, сохраняла бактерицидные свойства в течение 7 часов, тогда как плазма крыс, получивших обычный лизостафин, теряла любую активность уже спустя 4 часа.
Авторы статьи утверждают, что у них впервые упоминается антибактериальный лизин, обладающий одновременно улучшенными фармакокинетическими параметрами и продолжительной бактерицидной активностью в кровотоке.
"Лизостафин уже используют в Китае в составе препаратов местного применения, — рассказал нам Александр Гришин, ведущий автор исследования. — Некоторые другие противостафилококковые лизины находятся на стадии клинических исследований. Нашему же препарату до этого еще далеко. Мы хотим сначала повысить эффективность белковой конструкции. Сейчас у нас в процессе две работы, посвященные повышению ее активности. До начала клинических испытаний препарата еще не менее трех-четырех лет".
Работа выполнена при поддержке гранта РНФ.

